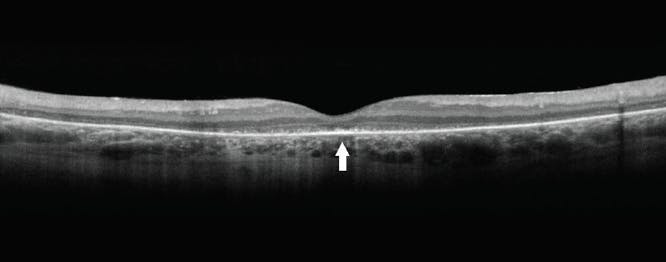
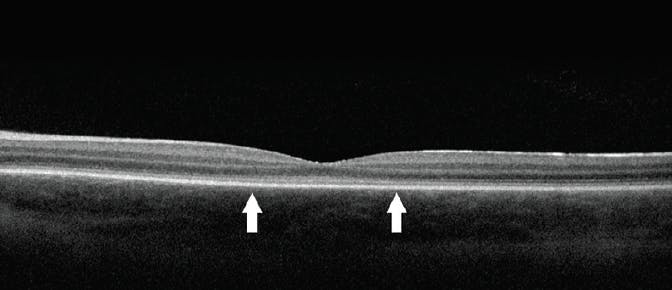

- Several nonprofit organizations and industry leaders have come together to provide free genetic testing programs for patients with an inherited retinal disease (IRD) diagnosis, including The Foundation Fighting Blindness My Retina Tracker program and the ID Your IRD program, developed in collaboration with Invitae.
- Patients and their parents must understand their genetic status to make informed decisions about clinical trial opportunities and participation.
- IRD gene registries can help researchers gain a better understanding of the heterogeneity of IRDs and the prevalence of different diseases and gene mutations.
Inherited retinal diseases (IRDs) are frequently diagnosed in early childhood, creating the potential for early intervention to correct the underlying genetic cause of disease and protect or improve patients’ vision in the long term. Until recently, there were no disease-modifying treatments for any IRD. As a result, genetic testing to determine the specific mutation that causes a patient’s IRD has not been broadly used. The landscape changed nearly 4 years ago, however, with the first FDA approval of a gene therapy for an IRD—Leber congenital amaurosis (LCA) due to mutations in the RPE65 gene.
This approval and the myriad clinical trials currently under way for other gene therapies have created a practical rationale for empowering patients to learn about their genetic status. As the field of IRD gene therapy continues to expand and progress, multiple stakeholders—including the eye health community, the biopharmaceutical industry, nonprofit organizations, and patients and their families—all have roles to play in realizing the potential benefits of intervention early in the disease process.
THE BENEFITS OF GENETIC TESTING
Given that many IRDs are progressive, early diagnosis and genetic assessment may help enhance patients’ ability to improve their long-term vision outcomes. Therefore, it is important to educate pediatric patients and their families about the availability and potential benefits of genetic testing as soon as an IRD diagnosis has been made or, for those already diagnosed, at the patients’ next visit.
Historically, genetic testing for IRDs has not been covered by health insurance because the results did not impact clinical practice or long-term prognosis. Recently, nonprofit organizations and industry leaders have come together to provide free testing for patients with an IRD diagnosis.
The Foundation Fighting Blindness My Retina Tracker program provides free testing for patients enrolled in the registry by their physician.1 The genetic testing panel available through this program currently evaluates 285 IRD-associated genes, including mitochondrial DNA testing. To perform the test, a genetic sample is collected using a simple blood draw or saliva sample done in the physician’s office or the patient’s home. The genetic sample, informed consent, and requisition for testing are returned to Blueprint Genetics, the Foundation’s industry testing partner, via a prepaid mailer.
The ID Your IRD program, developed in collaboration with Invitae, also offers free genetic testing for patients with a suspected IRD.2 This test evaluates 293 IRD-associated genes but does not currently include the RPGR gene associated with X-linked retinitis pigmentosa (XLRP, Figure 1). The test offered through ID Your IRD has enrollment, sample collection, and result processes similar to those for My Retina Tracker.
Figure 1. If a patient presents with signs suspicious for XLRP, as seen here, genetic testing may help confirm the diagnosis. The ID Your IRD panel does not include the RPGR gene; consider using the My Retina Tracker program instead.
Testing with either program can be ordered by any eye care provider for patients diagnosed with a covered IRD.
The genes evaluated in each panel are updated periodically, so patients with an IRD that is not currently included in a panel may be included in the future.
It is essential for patients and their parents to understand their genetic status to make informed decisions about clinical trial opportunities and participation. As new therapies hopefully gain approval in coming years, genetic status information will also help patients and parents learn which treatments might be appropriate for them.
GENETIC COUNSELING ESSENTIALS
Genetic testing is only the first step for patients with an IRD to become informed about their genetic status and related implications for clinical trial participation and therapeutic decisions. Genetic counseling is an essential component of genetic testing, and it is recommended that a genetic counselor be identified prior to undergoing testing to ensure that patients have access to an appropriate resource to help them understand their test results and discuss potential next steps.
In addition to answering questions about results, genetic counselors with expertise in IRDs may also be able to provide patients with information on relevant ongoing clinical trials. They also are well positioned to discuss potential IRD risks for parents who are considering having additional children.
Fortunately, with the expansion of molecular and precision medicine, there is a variety of resources available that can help connect IRD patients with a knowledgeable genetic counselor.
Some physician practices may have a genetic counselor on staff, whereas others may have a referral network of genetic counselors outside of their offices. Additionally, telephone-based genetic counseling is provided for free through both the My Retina Tracker and ID Your IRD programs.
IRD GENE REGISTRIES
Registries are essential resources to obtain insight into the natural history of specific IRDs and to collect information on the impact of different interventions (both disease-modifying and supportive) on patients’ experiences and ability to perform daily activities.
The My Retina Tracker registry is designed to achieve several objectives that will expand the collective understanding of IRDs and how to treat them.3 These objectives include gaining a better understanding of the heterogeneity of IRDs and the prevalence of the different diseases and gene mutations, assisting with the establishment of genotype-phenotype relationships, and improving the understanding of the natural history of specific IRDs.
Early diagnosis in the pediatric population provides an opportunity to better understand the natural history of early disease stages, when intervention may have more impact. Insights gained from analyzing registry data may accelerate research and development of clinical trials for treatments, and it may also provide a mechanism that facilitates more rapid recruitment for research studies and clinical trials.
My Retina Tracker collects data across an array of IRDs, but other IRD-specific registries and natural history studies are also available. For example, ProgStar is evaluating the natural history of Stargardt disease due to biallelic ABCA4 mutations.4 Other registries exist for several IRDs, including choroideremia, Usher syndrome (USH Trust), CRB1-related LCA/retinitis pigmentosa (RP), and blue cone monochromacy.
Patients who choose to particiate in these registries can make valuable contributions to our collective understanding of IRDs, and they may benefit by being notified when any clinical trial appropriate for their specific genetic mutation becomes available.
LIMITED TRIAL OPPORTUNITIES
There are more than 30 gene therapy clinical trials ongoing for diverse IRD indications, including XLRP, achromatopsia, LCA, RP due to a variety of genes, and others. Many of these trials, however, are open only to patients 18 years of age or older. Even fewer trials are open to children younger than 10, who may be the most likely to benefit from therapies that can prevent damage to or loss of retinal cells.
Although patient safety must always be paramount in drug development, pediatric patients should be included in IRD gene therapy trials as soon as favorable safety profiles have been established because of the potential benefit of visual function preservation.
Pediatric participation in IRD clinical trials is also essential for understanding the impact of investigational therapies at earlier stages of disease, when benefit may be greatest, and for generating robust clinical data that allow patients, parents, and physicians to make informed decisions about therapeutic options that are ultimately approved. Pediatric patients are currently being recruited for clinical trials evaluating gene therapy for XLRP and for CNGA3- or CNGB3-associated achromatopsia (Figure 2).
Figure 2. Certain pediatric patients with CNGA3- or CNGB3-associated achromatopsia may be eligible to enroll in clinical trials evaluating gene therapy.
COLLABORATING FOR IMPROVED OUTCOMES
The IRD gene therapy landscape is evolving rapidly, making it challenging to stay informed on the latest advances, especially those available to pediatric patients. Pediatric ophthalmologists, pediatric retina specialists, and genetic counselors who specialize in IRDs are valuable resources, as are many academic eye institutions.
Retina specialists should encourage patients to undergo IRD genetic testing and place a testing order if the patient with a suspected IRD is amenable. Advancing disease-modifying therapies for IRDs and giving pediatric patients new opportunities to preserve or improve their vision are communal responsibilities, and we can better achieve these important goals when we work together.
1. Foundation Fighting Blindness. My Retina Tracker Registry. Accessed June 4, 2021. www.fightingblindness.org/my-retina-tracker-registry
2. Invitae. ID Your IRD. Accessed June 4, 2021. www.invitae.com/en/idyourird
3. Inherited Retinal Degenerative Disease Registry (MRTR). Accessed June 4, 2021. clinicaltrials.gov/ct2/show/NCT02435940
4. Collison FT, Lee W, Fishman GA, et al. Clinical characterization of Stargardt disease patients with the p.N1868I ABCA4 mutation. Retina. 2019;39(12):2311-2325.























